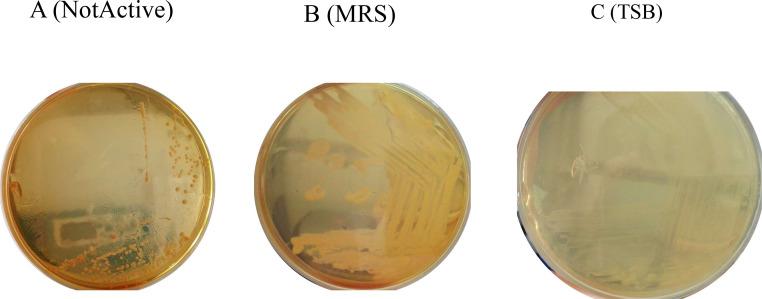
https://cdn.ncbi.nlm.nih.gov/pmc/blobs/f877/10958615/56f71810f295/gr1.jpg

双菌株益生菌对肉鸡生长、消化及肠道健康的影响。
Effects of duo-strain probiotics on growth, digestion, and gut health in broiler chickens.
作者信息
Mirsalami Seyed Mehrdad, Mirsalami Mahsa
机构信息
Department of Chemical Engineering, Faculty of Engineering, Islamic Azad University Central Tehran Branch, Tehran, Iran.
Faculty of Engineering and Technical Sciences, Qazvin Islamic Azad University, Qazvin, Iran.
出版信息
Vet Anim Sci. 2024 Mar 2;24:100343. doi: 10.1016/j.vas.2024.100343. eCollection 2024 Jun.
The goal of this inquiry was to analyze the impact of incorporating and using a novel premix-spray method on the following aspects: growth rate, digestive enzyme activity, antioxidant levels, gut microbiome composition, and the morphological characteristics of the duodenum, jejunum, and ileum in broiler chickens. Furthermore, this study explored the potential benefits of duo strains of probiotics (DSP) in reducing flatulence, regulating stool microbial population, and improving diarrhea symptoms. A total of 360 one-day-old mixed-sex Plymouth Rock chicks (IW: 51 ± 33 g) were randomly divided into two treatment groups. Each treatment group was further divided into 9 replicated cages, with 20 chicks housed in each cage. The control group (CG) received a basal diet composed of a soy-corn mixture, whereas the experimental group was provided with DSP (CON + 0.5 % probiotic). The results showed that the increase in the body weight of broilers at the end of the fourth week in the control group and the treatment group was 1.576 versus 1.847 kg, respectively. Throughout the 30-day trial period, the DSP diet significantly improved the specific growth rate (SGR), survival rate (SR), and body weight gain (BWG) while decreasing the feed conversion ratio (FCR) ( < 0.05). The DSP diet also enhanced the Enzymatic digestion (protease, amylase, lipase, and trypsin) and antioxidant potential (SOD, MDA, and catalase) of the broilers compared to those in the CG. The results revealed significant enhancements in the tissue morphology of the duodenum and jejunum following the combined treatment for a duration of 4 weeks. The DSP treatments significantly increased microvillus height in the duodenum and jejunum but had no notable effects in the ileum. Incorporating 0.5 % DSP in poultry feed improved the relative abundance of and , leading to better management of diarrhea and reduced presence of compared to the control diet. Additionally, including probiotics in the basal diet reduced HS, CO, NH, and CH levels. Overall, the study suggests that the new spray-drying approach with these strains has potential for supplementing probiotics in poultry feed processing, and including DSP in broiler chicken diets has beneficial effects.
本研究的目的是分析采用一种新型预混喷雾法对肉鸡生长速度、消化酶活性、抗氧化水平、肠道微生物群组成以及十二指肠、空肠和回肠形态特征等方面的影响。此外,本研究还探讨了双菌株益生菌(DSP)在减少肠胃胀气、调节粪便微生物群以及改善腹泻症状方面的潜在益处。总共360只1日龄的混合性别的普利茅斯洛克雏鸡(初始体重:51±33克)被随机分为两个处理组。每个处理组进一步分为9个重复笼,每个笼饲养20只雏鸡。对照组(CG)接受由大豆 - 玉米混合物组成的基础日粮,而实验组则饲喂DSP(对照组日粮 + 0.5%益生菌)。结果显示,对照组和处理组肉鸡在第四周结束时体重增加分别为1.576千克和1.847千克。在整个30天的试验期内,DSP日粮显著提高了特定生长率(SGR)、存活率(SR)和体重增加(BWG),同时降低了饲料转化率(FCR)(P<0.05)。与对照组相比,DSP日粮还增强了肉鸡的酶消化能力(蛋白酶、淀粉酶、脂肪酶和胰蛋白酶)和抗氧化能力(超氧化物歧化酶、丙二醛和过氧化氢酶)。结果表明,联合处理4周后,十二指肠和空肠的组织形态有显著改善。DSP处理显著增加了十二指肠和空肠的微绒毛高度,但对回肠没有显著影响。在禽类饲料中添加0.5%的DSP提高了[具体菌属]的相对丰度,与对照日粮相比,腹泻得到更好的控制,[有害菌属]的存在减少。此外,在基础日粮中添加益生菌降低了硫化氢、一氧化碳、氨气和甲烷的水平。总体而言,该研究表明,采用这些菌株的新型喷雾干燥方法在禽类饲料加工中补充益生菌具有潜力,并且在肉鸡日粮中添加DSP具有有益效果。